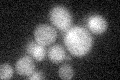
YMR269W
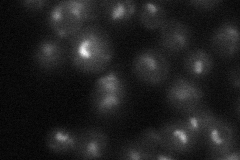
YMR269W
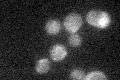
YMR269W

View description
Nucleolar protein of unknown function implicated in ribosome biogenesis; TMA23 may be a fungal-specific gene as no homologs have been yet identified in higher eukaryotes
Localization:
Intensity:
Fold change:
Significance:
-
C’ GFP library in SD
below threshold17.41 -
N' NOP1pr-GFP in SD

nucleolus122.629 -
N' TEF2pr-mCherry in SD

nucleus,nucleolus156.339 -
N' NATIVEpr-GFP in SD
nucleolus26.1585 -
N' TEF2pr-VC and Cyto-VN in SD

nucleolus33.5391 -
C’ GFP library in SD+DTT

cytosol16.880.96No -
C’ GFP library in SD+H2O2
cytosol15.730.9No -
C’ GFP library in Starvation Media

cytosol16.360.93No -
C’ GFP library on the background of Pup2-DaMP

below threshold -
C’ GFP library on the background of CCT mutant

below threshold15.42690.88561No
